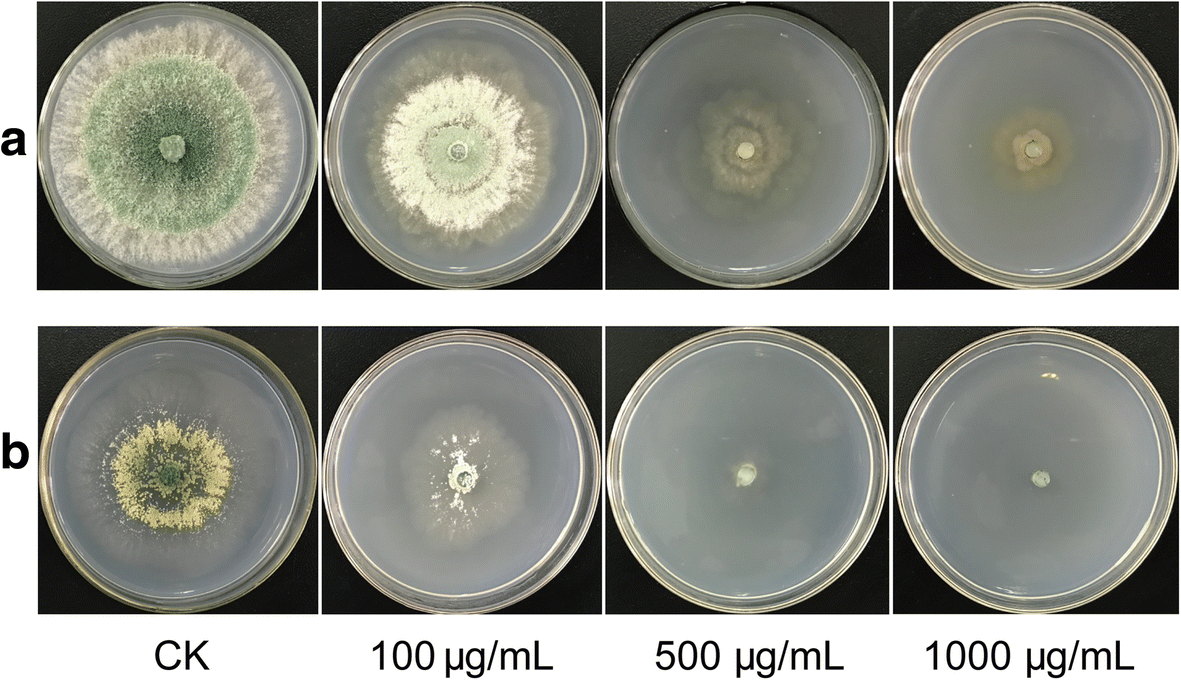

Триходерма Под Микроскопом Фото

⚡ 👉🏻👉🏻👉🏻 ВСЯ ИНФОРМАЦИЯ ДОСТУПНА ЗДЕСЬ, КЛИКАЙ 👈🏻👈🏻👈🏻
Форматы Фотографий Размеры Маленькие
Скачать Картинку Лето 2022
Порно Фото Моника Фуэнтес
Картинки С Понедельником Прикольные Смешные Надписью
Сорт Яблони Лигол Фото И Описание
Разукрашивать Картинки Самой
Каталог Фрески На Стену Фото В Интерьере
Заборы Смотреть Фото
Солнечная Система Своими Руками Картинки
Казахстан Картинки Для Детей
С Новым 1983 Годом Фото Москва
Как Установить Фото В Яндекс Такси
Индивидуалки Оренбурга С Реальными Фото
Фото Лицо Деньги
Перец Ингрид Описание Сорта Фото
Как Скопировать Текст В Ватсапе С Картинкой
Купить Каркасный Дом Фото Цена
Новая Тойота Прадо 2022 Фото Цена
Фото Бмв Классе
Много Коров Картинки
Parkwood Ltd Производители Столбов Фото
Творожная Пасха Фото
Фото Огурцов Адам
Фото И Описание Ядовитых Змей
Душа Сладкий Фото
День Перед Отпуском Картинки Прикольные
Скачать Фото К Презентации Ломоносов 3 Класс
Порно Фото Любительское В Попу
Красивые Русские Сексуальные Женщины Фото
Виноград Джонни Описание Сорта Фото Отзывы
Пермь Стрельба 2022 Фото Стрелка
Берегите Женщин Аккорды Картинки По Запросу
Тычковые Ножи Фото
Фото Черных Шотландских Вислоухих
Конек Горбунок Скачать Книгу С Картинками
Флаг Вьетнама Фото Картинки
Любительское Порно Фото Анал
Карнизы Для Штор Фото Минск
Добрый Вечер Картинки Гифки Скачать Бесплатно
Зима Лучшие Фото
Телефон Самсунг Зарядкой Фото
Дети Без Молочных Зубов Фото
Гиацинты Фото Цветов Букет
Овощное Поле Картинки Для Детей
Сорт Томата Киевлянка Описание Фото Отзывы
Фото Голой Жопы Смотреть Бесплатно
Фотография Главной Страницы Паспорта
Картинки Порно Бесплатно Скачать Живой
Обои Увеличивающие Комнату Фото
Скачать Фото Глажу Ее Попу
15 Фото Ландшафтного Дизайна
Картинки Больше Меньше Столько Же 1 Класс
Смешные Картинки С Пожеланиями Спокойной Ночи Женщине
Актриса Александра Яковлева Биография Личная Жизнь Фото
Фото Нового Тягача Мерседес
Пожилые В Чулках Анал Фото
Автобус Higer Фото
Сестра Пушкина Ольга Фото
Красные Огурцы Фото
Сорт Картофеля Крепыш Описание Сорта Фото
Красный Поцелуй Картинка
Стеклянные Лестницы На Второй Этаж Фото
Макияж Анны Фото
Волгоград Сталинградская Битва Фото
Неудержимые 1 Актеры Список И Фото
Схидно Промысловый Банк Октябрь 2022 Год Фото
Да Ты Ведьма Иван Васильевич Фото
Яндекс Диск Фото И Видео
Знаменитые Фотографии Вов
Томат Лучшие Описание Сорта Фото Отзывы
Фото Друг Убивает Друга
Приложение Чтобы Искать Видео По Фото 18
Печенье Макаруны Фото
Сделать Фото Со
Кабина Урал Некст Фото
Форма Челки Фото На Средние Волосы
Хвойные Дизайн Фото
Цвет Кала Новорожденных Фото
Отделка Домов Кирпич Фото
Диско 90 Фото
Ламинат Серый Дуб В Интерьере Фото
Молочайные Комнатные Растения Фото И Названия
Картинки Пдд Для Школьников Дорожные
Самые Милые Фото Котов
Лоток Для Кошки Цена Фото
Татуировка Лиса Фото
Розанова Ирина Фото В Молодости
Олег Табаков Биография Дети Фото
Фотографии Авто По Гос Номеру
Скачать Фото Цветов В Вазе
Жук Кошениль Фото
Частное Порно Фото Галерея Зрелых
Завтрак Зимой Фото
Лестница На Второй Этаж В Квартире Фото
Киа Рио Фото Двигателя
Порода Собаки Кокер Спаниель Картинки
Зимостойкие Розы С Описанием И Фото
Фото Секси Женщин
Чем Отличаются Пассатижи От Плоскогубцев Покажи Фотографии
Перец Знатный Толстяк Описание Сорта Фото Отзывы
Пятница Поздравления В Картинках Прикольные Скачать
Валериан Владимирович Куйбышев Фото
Мария Буше Фото
Триходерма Под Микроскопом Фото








I_MWS65914.jpg" width="550" alt="Триходерма Под Микроскопом Фото" title="Триходерма Под Микроскопом Фото">































I_MWS65887.jpg" width="550" alt="Триходерма Под Микроскопом Фото" title="Триходерма Под Микроскопом Фото">